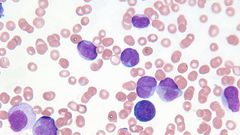

A blood-based cancer, leukemia occurs when bone marrow cells start dividing and multiplying at a rapid pace, severely limiting the body's ability to produce red and white blood cells. In 2014, an estimated 387,000 people in the U.S. were living with a form of leukemia, according to the National Cancer Institute . And as we've seen in the movies, leukemia can be fast-acting, debilitating, and extremely lethal.
Exactly how lethal leukemia is depends on its typechronic or acute, says Anne Renteria, M.D., assistant professor of medicine, hematology, and medical oncology at Mt. Sinai Hospital in New York City.
When a patient has chronic leukemia, cancer cells are found in the patient's blood and bone marrow, but they don't rapidly and aggressively divide. Chronic leukemias are most often found during routine blood work and are managed either with observation or a chemotherapy pill. Very often the cancer is in your bone marrow, but it's not making you sick. People with CML and CLL work and pretty much live a normal life, she says.
But acute leukemias are a different beast altogether, and you're likely seeing an acute form of the cancer when you see leukemia portrayed on the big screen. Acute leukemias are aggressive, and typically exhibit extreme symptoms before they're diagnosed, she explains.
That's why, if you're experiencing any leukemia symptoms, it's best to play it safe and get to the doctor immediately."You need to see someone like a primary-care physician who has a broad understanding of how the body works," she says.
So what are the symptoms of leukemia that you should you watch out for? Here are seven most common ones.
Paleness
When someone develops acute leukemia, the cancer cells in their bone marrow divide so rapidly that the body has little chance to produce other components that make up our blood, such as red blood cells, Renteria explains. When red blood cells are lower than normal (a condition called anemia), your skin loses its normally rosy, healthy glow, resulting in a complexion several shades lighter than your usual skin tone, she says.
Your doctor will likely perform a blood test to determine your red blood cell count.
Fatigue
One of the hallmark symptoms of acute leukemias is fatigue. Exhaustion is something we all kind of consider to be normal," says Renteria, but when you're disproportionately tired, or find yourself unable to get through simple chores without falling asleep, it's time to do something about it. It's a problem when the regular crazy life you were once able to tolerate suddenly becomes intolerable, she says.
While cancer-related fatigue isn't yet completely understood, it's possible that cancer alters hormone levels in the body while also producing toxic substances that interfere with energy levels, according to the American Cancer Society . Cancer-caused anemia can also play a role.
Related: 5 Signs Your Exhaustion Is A Symptom Of A Much Bigger Problem
Bruising Easily
Rapidly dividing cancer cells also damage blood vessels and push out platelets, which are necessary for clotting blood. When blood can't clot, bruising appears, Renteria explains
If you're getting a lot of bruising seemingly out of nowhere, or if you're finding bruises in unusual places, like your back, call your doctor STAT, she says. It's important to address any internal bleeding before it causes serious complications or even death.
Watch a hot doctor explain why that stubborn bruise won't heal:
Excessive bleeding
Similarly to bruising, a lack of plateletswhich cause blood to clotcan result in unusual or excessive bleeding. Some people may experience sudden bleeding from their gums or nosebleeds; others might notice that a routine paper cut takes a lot longer to properly heal, she says.
If you experience any unusual or excessive bleeding, get immediate care.
Related: 8 Reasons Why Your Period Is Suddenly Shorter Than Normal
Heart Palpitations
Leukemia can cause heart palpitations after even mild exertion, according to Renteria. Your heart is having to work twice as hard to make up for the lack of red blood cells, she says. Patients with pre-existing heart conditions who develop leukemia might also experience chest pains.
This should go without saying, but if your heart is acting up, have someone take you to the emergency room.
Constant Sickness
Bone marrow cells also inhibit the formation of white blood cells, which fight infection. As a result, someone with leukemia may start getting frequently sick, or have sicknesses that last far longer than normal. A flu or a cold that might normally last five days starts lasting two weeks, Renata explains. You might start having fevers a lot or develop pneumonia. You're just sick all the time.
So, if you have a cold you just can't shake , or many in a row, it may be time to head to the doctor.
Related: 'How I Told My Partner That I'm HIV-Positive'
Night Sweats
Night sweats are very common with acute leukemiabut unfortunately, doctors don't know exactly why, Renteria says. Some experts say it may be related to hormones; others, a substance that your blood cells release in order to fight the cancer.
If you're normally a pretty sweaty girl, there's probably no reason to freak out, but if night sweats crop up for seemingly no reason at all, talking to your doc can't hurt.

&format=jpeg)
&format=jpeg)
&format=jpeg)
![Can Sucking a Woman’s Breast Really Reduce Breast Cancer Risk? Health Expert Sets the Record Straight [FemTechWorld]](https://image.api.sportal365.com/process/smp-images-production/pulse.com.gh/28102024/0ab74935-e607-44be-8728-0ffbfee9e382?operations=autocrop(140:79)&format=jpeg)